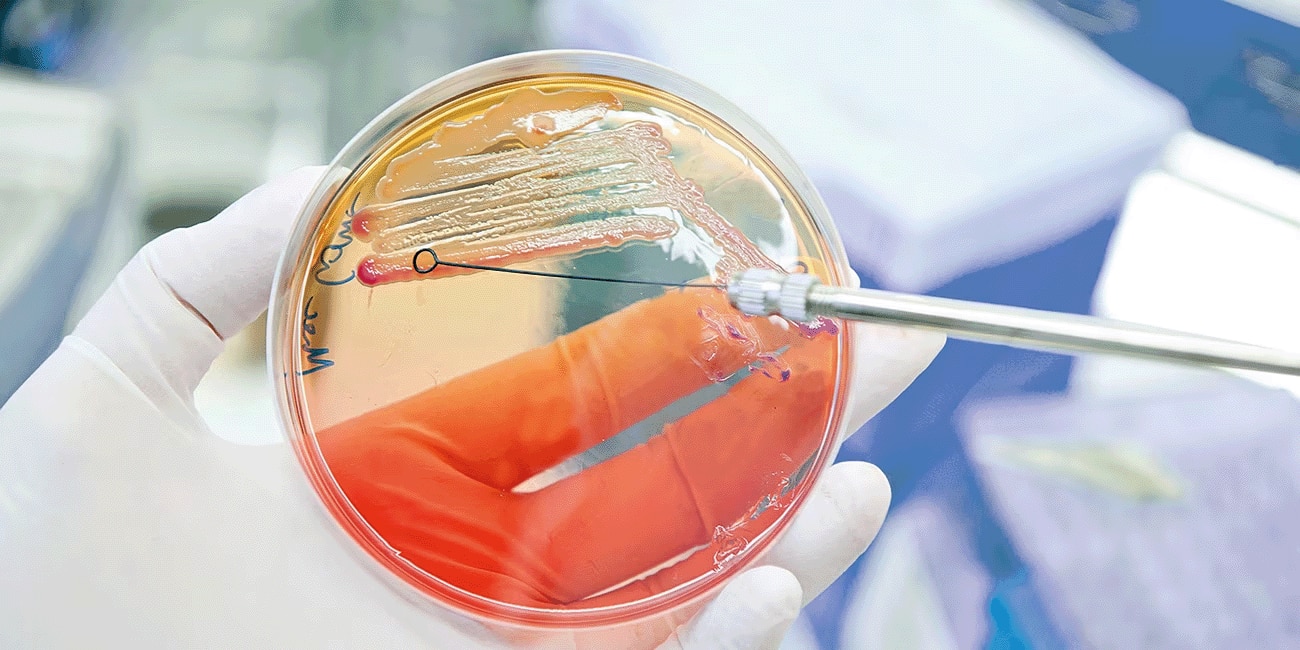

Ihr Partner für Patientensicherheit
Im Mittelpunkt jeder qualitätsorientierten Gesundheitsversorgung steht die Sicherheit des Patienten
"Unter Patientensicherheit versteht man die Abwesenheit unerwünschter Ereignisse bei der Versorgung von Patienten im Gesundheitswesen.2"
Aktionsbündnis Patientensicherheit

Bei BD arbeiten wir mit regionalen Arbeitskreisen für Patientensicherheit zusammen, um Menschen zu befähigen, diese Geschichten in unserem gemeinsamen Bestreben nach einer besseren Patientenversorgung zu erzählen.

Unerwünschte Ereignisse sind insgesamt für 15 Prozent aller Versorgungskosten in der Klinik verantwortlich.3
Nosokomiale Infektionen, Sepsis, Antibiotikaresistenzen und Medikationsfehler verursachen über 65 Prozent der Krankheitslast aller unerwünschten Ereignisse und der damit verbundenen Kosten.1

Unerwünschte Ereignisse, die das ungewollte Ergebnis einer Behandlung sind, gefährden die Patientensicherheit und belasten das Gesundheitssystem.3,29
Viele dieser unerwünschten Ereignisse gehen auf Fehler zurück, die infolge komplexer und arbeitsteiliger Abläufe entstehen.29,42
Daher erfordert die Reduzierung unerwünschter Ereignisse eine Sicherheitskultur und einen multidisziplinären, systemischen Ansatz des gesamten Krankenhauses.43

Jährlich ereignen sich in Deutschland 400.000 bis 600.000 nosokomiale Infektionen.4
Schätzungen zufolge verursachen multiresistente Bakterien Kosten von über 1,5 Milliarden Euro pro Jahr.7

Sepsis und septischer Schock sind mit erhöhter Morbidität und einem sehr hohen Mortalitätsrisiko verbunden.44

Standardisierte Medikationsprozesse, vollständige Rückverfolgbarkeit, Automatisierung und ein geschlossener Medikationsmanagementkreislauf können Ihnen helfen, Medikationsfehler zu vermeiden.
Eine offene Sicherheitskultur und ein ganzheitlicher Systemansatz sind entscheidend für die Verbesserung der Patientensicherheit3
"Menschliches Versagen ist unvermeidlich... Es ist die Systemebene, auf der wir den Schaden für den Patienten verhindern müssen."
(Liam Donaldson, WHO Weltgesundheitsorganisation)
Mit einem einzigartigen Portfolio an Produkten, Dienstleistungen und Fähigkeiten unterstützt BD Sie in folgenden Bereichen: Erhaltung einer Sicherheitskultur, Vorbeugung von Sicherheitsvorfällen auf dem gesamten Weg des Patienten, Implementierung sicherer, innovativer und optimierter Technologien zur Verbesserung der Patientensicherheit, Gewährleistung der Sicherheit des Personals im Gesundheitswesen, Erreichen von Messwerten, die aussagekräftige Ergebnisse widerspiegeln.
BD unterstützt Sie bei der Vorbeugung und Behandlung von krankenhausassoziierten Infektionen
BD unterstützt Ihr Sepsis-Diagnose- und Behandlungsmanagement
BD unterstützt Sie bei der Umsetzung von Antimicrobial-Stewardship-Programmen
BD unterstützt Sie bei der Reduzierung von Fehlern von der Diagnostik bis zur Medikamentenverabreichung
BD unterstützt den Wandel und die kontinuierliche Qualitätsverbesserung
1. Frost & Sullivan. Patient Safety in Healthcare, Forecast to 2022: Investment Trends, Growth Opportunities, Challenges, and Future Perspectives. 2017.
2. Aktionsbündnis Patientensicherheit e.V.. Glossar. Accessed on November 17, 2022, at https://www.pro-patientensicherheit.de/fileadmin/Medienablage/Dokumente/Aktionsb%C3%BCndnis_PatSi/Aktionsbuendnis-Patientensicherheit-Glossar-.pdf
3. Slawomirski L, Auraaen A, Klazinga N. The economics of patient safety: Strengthening a value-based approach to reducing patient harm at national level. Health Working Papersem. 2017;96.
4. Gastmeier P, Geffers C, Hermann M, et al. Nosokomiale Infektionen und Infektionen mit multiresistenten Erregern - Häufigkeit und Sterblichkeit. Deutsche Medizinische Wochenschrift. 2016; 141:421–426. doi: 10.1055/s-0041-106299
5. Arefian H, Hagel S, Heublein S, et al. Extra length of stay and costs because of health care – associated infections at a German university hospital. Am J Infect Control. 2016; 44(2):160-6. doi: 10.1016/j.ajic.2015.09.005
6. Cassini A, Plachouras D, Eckmanns T, et al. Burden of six healthcare associated infections on European population health: Estimating incidence-based disability- adjusted life years through a prevalence-based modelling study. PLoS Med. 2016; 13(10): e1002150. doi: 10.1371/journal.pmed.1002150
7. European Commission. A European One Health Action Plan against Antimicrobial Resistance (AMR); 2017. Accessed on November 17, 2022, at https://health.ec.europa.eu/system/files/2020-01/amr_2017_action-plan_0.pdf
8. O‘Neill J. Tackling drug-resistant infections globally: Final report and recommendations. The review on antimicrobial resistance. 2016.
9. Fleming-Dutra, K et al. Prevalence of inappropriate antibiotic prescriptions among US ambulatory care visits, 2010–2011. Journal of the American Medical Association. 2016; 315(17):1864-73. doi: 10.1001/jama.2016.4151.
10. Prävention von Infektionen, die von Gefäßkathetern ausgehen: Teil 1 – Nichtgetunnelte zentralvenöse Katheter Empfehlung der Kommission für Krankenhaushygiene und Infektionsprävention (KRINKO) beim Robert Koch-Institut. Bundesgesundheitsblatt Gesundheitsforschung Gesundheitsschutz. 2017; 60(2):171-206. German. doi: 10.1007/s00103-016-2487-4. Erratum in: Bundesgesundheitsblatt Gesundheitsforschung Gesundheitsschutz. 2018 Mar 21; PMID: 28091692
12. Fleischmann C, Thomas-Rueddel DO, Hartmann M, et al. Fallzahlen und Sterblichkeitsraten von Sepsis-Patienten im Krankenhaus. Deutsches Ärtzteblatt Int. 2016; 113(10):159-66.
16. Seymour CW, Gesten F, Prescott H, et al. Time to treatment and mortality during mandated emergency care for sepsis. New England Journal of Medicine. 2017; 376:2235–2244. doi: 10.1056/NEJMoa1703058
17. Singer M, Deutschman CS, Seymour CW, et al. The Third International Consensus Definitions for Sepsis and Septic Shock (Sepsis-3). JAMA. 2016; 315(8):801-10. doi: 10.1001/jama.2016.0287
18. Kumar A, Roberts D, Wood KE, et al. Duration of hypotension before initiation of effective antimicrobial therapy is the critical determinant of survival in human septic shock. Crit Care Med. 2006; 34:1589–1596. doi: 10.1097/01.CCM.0000217961.75225.E9.
19. Prasad PA, Shea ER, Shiboski S, et al. Relationship Between a Sepsis Intervention Bundle and In-Hospital Mortality Among Hospitalized Patients: A Retrospective Analysis of Real-World Data. Anesth Analg. 2017; 125(2):507-513. doi: 10.1213/ANE.0000000000002085
21. Bundesinstitut für Arzneimittel und Medizinprodukte. Medikationsfehler als Ursache für Krankenhauseinweisungen: Bundesinstitut für Arzneimittel und Medizinprodukte startet neues Forschungsprojekt. Pressemitteilung Nummer 17/14 vom 28.11.2014. Accessed on November 28, 2022, at https://www.bfarm.de/SharedDocs/Pressemitteilungen/DE/2014/pm17-2014.html
22. World Health Organization (WHO). Medication Without Harm - Global Patient Safety Challenge on Medication Safety. Geneva: 2017. Licence: CC BY-NC-SA 3.0 IGO
23. Kaushal R, Bates DW, Landrigan C, et al. Medication Errors and Adverse Drug Events in Pediatric Inpatients. JAMA. 2001; 285(16):2114-20. doi: 10.1001/jama.285.16.2114
24. Ross LM, Wallace J, Paton JY. Medication errors in a paediatric teaching hospital in the UK: five years operational experience. Arch Dis Child. 2000; 83(6):492–7. doi: 10.1136/adc.83.6.492
25. Baehr M, et al. Kopplung von elektronischer Verordnung und patientenorientierter Logistik, Krankenhauspharmazie. 2014; 35:110–7.
26. Buddrus U. HIMSS Europe. Closed Loop Medication Process – Der elektronische Arzneimittelversorgungsprozess. 2014.
27. Prävention postoperativer Wundinfektionen: Empfehlung der Kommission für Krankenhaushygiene und Infektionsprävention (KRINKO) beim Robert Koch-Institut. Bundesgesundheitsblatt Gesundheitsforschung Gesundheitsschutz. 2018 Apr;61(4):448-473. German. doi: 10.1007/s00103-018-2706-2. PMID: 29589090
28. Leupold F. Evaluation der Handlungsempfehlungen des Aktionsbündnis Patientensicherheit. Berlin 2019. Accessed on November 11, 2022 at https://www.aps-ev.de/wp-content/uploads/2019/04/Evaluation_APS_HE_Leupold.pdf
29. Klauber J, Geraedts M, Friedrich J, Wasem J. Krankenhaus-Report 2014. Schwerpunkt: Patientensicherheit. Schattauer. 2014.
30. Bates DW, Cullen DJ, Laird N, et al. Incidence of adverse drug events and potential adverse drug events. Implications for prevention. ADE Prevention Study Group. JAMA. 1995; 274(1):29-34. PMID: 7791255
31. Aly A-F. Ein „Was ist Was“ der Sicherheit. Deutsches Ärzteblatt. 2014; 111(44): A-1892 / B-1618 / C-1550.
32. Vincent JL. Increasing awareness of sepsis: World Sepsis Day. Crit Care. 2012; 16(5):152. doi: 10.1186/cc11511
33. Weltgesundheitsorganisation (WHO). 31 July 2020. Fact Sheet. Antibiotic resistance. Accessed on November 11, 2022 at https://www.who.int/news-room/fact-sheets/detail/antibiotic-resistance
34. Streamlining EMA public communication on medication errors. European Medicines Agency; 2015.
35. Fleischmann-Struzek C, Mikolajetz A, Schwarzkopf D, et al. Challenges in assessing the burden of sepsis and understanding the inequalities of sepsis outcomes between National Health Systems: secular trends in sepsis and infection incidence and mortality in Germany. Intensive Care Med. 2018; 44(11):1826-1835. doi: 10.1007/s00134-018-5377-4
36. Levy MM, Evans LE, Rhodes A. The Surviving Sepsis Campaign Bundle: 2018 update. Intensive Care Med. 2018; 44(6):925-928. doi: 10.1007/s00134-018-5085-0
37. Kim H, Park S. Sepsis: Early Recognition and Optimized Treatment. Tuberculosis and Respiratory Diseases. 2018; 82(1): 6–14. doi: 10.4046/trd.2018.0041
38. Arefian H, Heublein S, Scherag A, et al. Hospital-related cost of sepsis: A systematic review. J Infect. 2017;74(2):107-117. doi: 10.1016/j.jinf.2016.11.006
39. Shorr A, Micek S, Jackson W, et al. Economic implications of an evidence-based sepsis protocol: Can we improve outcomes and lower costs?. Critical care medicine. 2007; 35. 1257-62. doi: 10.1097/01.CCM.0000261886.65063.CC
40. Angus D., Seymour C, Coopersmith C, et al. A Framework for the Development and Interpretation of Different Sepsis Definitions and Clinical Criteria. Critical Care Medicine. 2016; 44. e113-e121. doi: 10.1097/CCM.0000000000001730.
41. S3-Leitlinie “Prävention, Diagnose, Therapie und Nachsorge der Sepsis”. Stand: 31.12.2018 , gültig bis 30.12.2023. https://register.awmf.org/assets/guidelines/079-001l_S3_Sepsis-Praevention-Diagnose-Therapie-Nachsorge_2020-03_01.pdf
42. Bundesministerium für Gesundheit. Behandlungsfehler. Accessed on November 17, 2022, at https://www.bundesgesundheitsministerium.de/themen/praevention/patientenrechte/behandlungsfehler.html
43. Lawati MHA, Dennis S, Short SD, Abdulhadi NN. Patient safety and safety culture in primary health care: a systematic review. BMC Fam Pract. 2018; 19(1):104. doi: 10.1186/s12875-018-0793-7
44. Martin G. Sepsis, severe sepsis and septic shock: Changes in incidence, pathogens and outcomes. Expert review of anti-infective therapy. 2012; 10(6): 701–706. doi: 10.1586/eri.12.50
